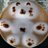

企画概要
【トワ様】常闇トワ様にフラワースタンドを送りませんか?【祝2ndソロライブ開催】
SNSでシェア
同じ日に開催される企画
-
常闇トワ様2ndソロライブを記念してフラワースタンドを送りませんか?
calendar_month 2025/10/29
location_on 有明アリーナ
トワ様のライブを最高のライブにしましょう
参加










72人
募集終了
企画完了 -
常闇トワ2ndLive応援広告企画
calendar_month 2025/10/29
location_on 国際展示場駅、東京駅
トワ様へ応援広告を贈りませんか?!
参加










158人
募集終了
企画完了 -
常闇トワ様の2ndソロライブへお花を贈りませんか?
calendar_month 2025/10/29
location_on 有明アリーナ
トワ様に喜んでいただけるよう頑張ります!
参加










68人
募集終了
企画完了 -
【トワ様2ndソロライブ記念】常闇トワ様へフラワースタンドを送りませんか?
calendar_month 2025/10/29
location_on 有明アリーナ
初めてのフラスタ主催ですが頑張ります!
参加










111人
募集終了
企画完了 -
2ndソロライブ開催を記念して常闇トワ様にお花を贈りませんか?
calendar_month 2025/10/29
location_on 有明アリーナ
トワ様を笑顔に出来るよう頑張ります!
参加










142人
募集終了
企画完了 -
【トワ様】常闇トワ様へフラスタを送りませんか?!【2ndソロライブ記念】
calendar_month 2025/10/29
location_on 有明アリーナ
トワ様にみんなでフラスタを贈りましょう!
参加










230人
募集終了
企画完了 -
常闇トワ2ndソロライブ「SHINier」フラワースタンド企画
calendar_month 2025/10/29
location_on 有明アリーナ
トワ様を笑顔にしたい!そんな企画です!
参加










142人
募集終了
企画完了 -
狂蘭メロコ お誕生日広告 / Meloco Bday billboard project
calendar_month 2025/10/29
location_on 東京都内 某駅, 大阪府内 某駅
皆さんで素敵なお祝いにできたら嬉しいです
参加










85人
募集終了
企画完了